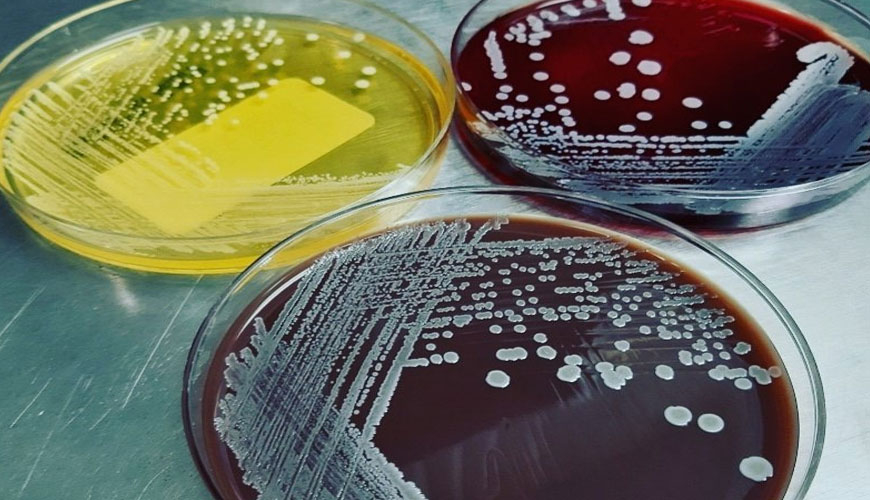

فروش سویه استافیلو کوکوس اریوس کد ATCC6538
شرکت اینترنتی تمادکالا از فروشندگان اینترنتی مواد شیمیایی و بیولوژیکی، سویههای مختلف جهت کاربرد در آزمایشگاههای بیولوژیکی را به مشتریان ارائه میدهد. جهت آگاهی از خصوصیات سویه استافیلو کوکوس اریوس کد ATCC6538 میتوانید بخشهای بعدی را مشاهده نمایید. باکتریها با توجه به ساختار ژنتیکی خود به گونه و سوش هایی طبقه بندی میشوند. سوش یا سویه باکتریایی سلولهای باکتریایی مشتق شده از یک سلول منفرد با ژنتیکی تقریبا یکسان هستند. سویهها در مقایسه با گونهها، تنوع ژنتیکی کمتری دارند و در کمتر از 10 درصد ژنهای خود با یکدیگر تفاوت دارند. برای مقایسه بهتر و دقیق تر این سویه ها، سوشهای استانداردی توسط مراکز معتبری مانند American Type Culture Collection (ATCC) نگهداری و توزیع میشوند. آنها به عنوان مرجع برای شناسایی و طبقهبندی باکتریها استفاده میشوند.
سویه استافیلوکوکوس اورئوس (ATCC 6538) یکی از این سویه های استاندارد است که به طور گسترده در تحقیقات میکروبیولوژی استفاده می شود. این سویه به عنوان یک استاندارد برای آزمایش و ارزیابی فعالیت ضد میکروبی و همچنین برای بررسی ویژگی های بیولوژیکی استافیلوکوکوس اورئوس استفاده می شود. سوش باکتری استافیلوکوکوس اورئوس مناسب برای رشد باکتری استافیلوکوکوس اورئوس است. این استاندارد برای اهداف تحقیقاتی استفاده میشود و نباید برای تشخیص یا درمان استفاده شود. به جز سویه ATCC 6538 که یک سویه استاندارد است سویه های دیگر استافیلوکوکوس اورئوس وجود دارند که میتوانند مقاومت دارویی متفاوتی داشته باشند. استافیلوکوکوس اورئوس یک باکتری و کوکسی گرم مثبت است. در بینی و روی پوست افراد یافت میشود و میتواند باعث ایجاد عفونتهای مختلفی مانند عفونت پوستی شود. همچنین میتوانند باعث ذاتالریه، عفونت دریچههای قلب و عفونت استخوان نیز شود. یک باکتری بیماری زا است و در زیر میکروسکوپ به شکل خوشه و زرد طلایی دیده میشود. این باکتری با تولید انتروتوکسین، باعث مسمومیت غذایی می شود.
خرید انواع سوش باکتری
ویژگی های سویه استافیلو کوکوس اریوس کد ATCC6538
- یک باکتری گرم مثبت و کروی
- به طور طبیعی حضور در محیط های مختلف از جمله پوست و بینی انسان
کاربردهای سویه استافیلو کوکوس اریوس کد ATCC6538
- شناسایی بهتر استافیلوکوکوس اورئوس و بررسی راه های مقابله با عفونت های ناشی از این باکتری کاربرد در بیوانفورماتیک و تحقیقات بیماریهای عفونی
- در آزمایشگاه های میکروبیولوژی جهت کنترل کیفی، حساسیت به آنتی بادی و ارزیابی مقاومت باکتریایی
- در فرایند تولید داروهای جدید در داروسازی برای بررسی اثر دارو یا آنتیبیوتیک روی سویههای حساس و مقاوم در مطالعات تجربی مربوط به عارضه های عفونت زا
- برای اهداف تحقیقاتی، مانند ارزیابی اثربخشی ضد میکروبی داروها و بررسی مکانیسمهای مقاومت دارویی
- در صنایع دارویی و آرایشی جهت بررسی عملکرد و اثر ضدعفونیکنندهها و آنتیبیوتیکها در برابر این باکتری
- یک باکتری پرکاربرد برای بررسی مکانیسمهای بیماریزایی
- در تحقیقات میکروبیولوژی برای بررسی محیطهای کشت، شناسایی باکتری و حساسیت آنتیبیوتیکی
- آزمایش مواد غذایی و آزمایش آب
- کاربرد در آزمون بررسی تمیز بودن مواد و دستگاهها
- به دلیل مقاومت کم این سویه به دارو بسیار کاربردی و مفید برای تستهای پایهای
- کاربرد در آزمایش افزایش رشد، آزمایش اثربخشی، آزمایش بازدارندگی، آزمایش عوامل ضدمیکروبی و به عنوان یک میکروارگانیسم آزمایشی در روشهای مختلف آزمایش
کاربرد معمول سویهها
- مطالعه ژن ها، جهش ها و مقاومت دارویی
- برای تولید واکسن انتی بیوتیک
- تشخیص بیماری و کشت باکتری در آزمایش های تشخیص طبی
- مطالعه اپیدمیولوژی
محیطهای کشت مناسب این باکتری
- Nutrient agar
- Tryptic Soy Agar (TSA)
- Blood Agar
خرید سویه استافیلو کوکوس اریوس کد ATCC6538
برای خرید سویه استافیلو کوکوس اریوس کد ATCC6538 هم اکنون میتوانید از طریق همین صفحه از سایت فروشگاه اینترنتی تمادکالا اقدام نمایید. در صورت نیاز به مشاوره و راهنمایی در خرید، میتوانید از طریق راههای ارتباطی با کارشناسان ما در بخش فروش در ارتباط باشید.